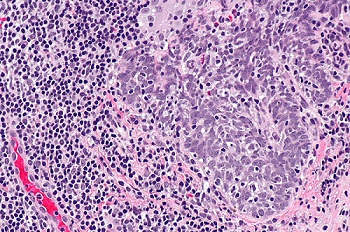

微信掃描二維碼,點擊右上角 ··· 按鈕
轉(zhuǎn)發(fā)給朋友或分享到朋友圈
顯微成像·洞察微觀之美
Microscopic imaging, insight into the beauty of micro
顯微鏡怎樣看病毒,病毒學(xué)研究用什么顯微鏡?
發(fā)布時間:2025-10-10
訪問量:168
一、病毒
病毒是一種個體微小,結(jié)構(gòu)簡單,只含一種核酸(DNA或RNA),需要在活細胞內(nèi)寄生并以復(fù)制方式增殖的非細胞型生物。病毒是一種非細胞生命形態(tài),它由一個核酸長鏈和蛋白質(zhì)外殼構(gòu)成,病毒沒有自己的代謝機構(gòu),沒有酶系統(tǒng)。因此病毒離開了宿主細胞,就成了沒有任何生命活動、也不能獨立自我繁殖的化學(xué)物質(zhì)。它的復(fù)制、轉(zhuǎn)錄和轉(zhuǎn)譯的能力都是在宿主細胞中進行,當(dāng)它進入宿主細胞后,它就可以利用細胞中的物質(zhì)和能量完成生命活動,按照它自己的核酸所包含的遺傳信息產(chǎn)生和它一樣的新一代病毒。

流感病毒渲染圖
二、光學(xué)顯微鏡在病毒學(xué)研究中的應(yīng)用
相比于常見細胞的幾十微米級別尺寸,病毒的尺寸小很多,一般在60-220nm,而受制于可見光的衍射峰值,光學(xué)顯微鏡無法分辨200nm以下的物體,因此無法對病毒進行結(jié)構(gòu)尺度的觀測,目前應(yīng)用光學(xué)顯微鏡對病毒進行觀測研究主要是從以下兩個方面著手:
(1)通過觀測對病毒進行特異性標記產(chǎn)生的熒光信號,從而實現(xiàn)對病毒位置數(shù)量的判斷。病毒主要由核酸和蛋白質(zhì)組成,常見的一種方法是利用熒光標記的特異核酸探針與病毒含有的靶DNA分子或RNA分子進行雜交,可通過在熒光顯微鏡下觀察熒光信號,來確定與特異探針雜交后被染色的病毒的分布和數(shù)量,這種方式也稱為原位熒光雜交技術(shù)(FISH)。

FISH做的病毒檢測,紅色為病毒外殼蛋白
(引自公開論文https://doi.org/10.1073/pnas.1820132117)
(2)通過檢測病毒入侵導(dǎo)致細胞產(chǎn)生的免疫物質(zhì)或病理形態(tài)變化,從而判斷病毒種類、分布和數(shù)量。正常細胞在面對病毒入侵時,會發(fā)生免疫反應(yīng),產(chǎn)生的免疫物質(zhì)就可作為熒光染料標記的結(jié)合物,通過熒光顯微鏡對免疫熒光信號進行觀測從而做出檢測判斷,這種通過對免疫蛋白進行標記的方式也稱之為免疫熒光(IF),這種方式在臨床上常見的應(yīng)用有呼吸道七聯(lián)檢或九聯(lián)檢。

呼吸道七聯(lián)檢免疫熒光,MF31拍攝(綠色為病毒反應(yīng))
應(yīng)用類似原理,還有不使用熒光染色的免疫組化(IHC)染色,主要用于尸檢研究,判斷病毒對身體各器官的感染情況,比如新冠病毒和猴痘病毒都能找到相關(guān)研究。

IHC免疫組化染色,猴痘病毒感染犬的支氣管(紅色為病毒反應(yīng))
病毒入侵也會導(dǎo)致細胞或組織發(fā)生病理變化,如感染細胞與未感染細胞的胞漿膜發(fā)生融合,形成多核的巨細胞,或某些病毒感染細胞時,在光學(xué)明場顯微鏡下可見胞漿或胞核內(nèi)出現(xiàn)嗜酸或嗜堿性染色、大小不同和數(shù)量不等的圓形或不規(guī)則的團塊結(jié)構(gòu),如HPV人乳頭狀瘤病毒。
HPV引起,分化不良的鱗狀細胞癌
三、顯微成像技術(shù)在病毒觀測中的挑戰(zhàn)
根據(jù)上述光學(xué)顯微鏡對病毒的檢測方式,主要有兩種方式,一是使用熒光顯微鏡檢測熒光染料標記病毒本身的熒光信號或入侵細胞免疫反應(yīng)產(chǎn)生抗體物質(zhì)熒光信號,二是使用明場方式觀測IHC或者HE染色的細胞或組織的病理形態(tài)。
主要的挑戰(zhàn)來自病毒本身體積小,含量相對較低,導(dǎo)致熒光染料產(chǎn)生的熒光信號弱,需要使用較強的激發(fā)光與高靈敏度的顯微相機進行成像;使用免疫熒光方式檢測病毒對特異性染料的選擇及熒光顯微鏡濾光片的選擇要求較高,需要保證病毒標志物熒光信號不被其它種類的熒光信號所覆蓋,對通道的選擇及熒光圖像軟件的合成有很高的要求。

MF23搭配MC50-S拍攝的呼吸道病毒檢測
四、明美推薦方案

(1)醫(yī)院呼吸七聯(lián)檢、九聯(lián)檢等免疫熒光檢測
推薦:MF23/MF31 + 顯微鏡相機MC50-S/MD60/MD50-T等
? 長壽命LED熒光模塊,即開即用,使用方便,激發(fā)效果穩(wěn)定
? 可選單通道激發(fā)或數(shù)顯多通道激發(fā),各通道可獨立連續(xù)調(diào)節(jié)
? 相機針對顯微成像優(yōu)化,可滿足對實時性要求低的熒光成像

(2)宮頸癌HPV感染篩查和病毒研究等需要FISH檢測的應(yīng)用
推薦:MF43-N+寬光譜大功率光源MG-100/MG-120+高靈敏度相機MC50-S/MS23+FISH軟件
? 研究級機身,6孔落射熒光模塊,高數(shù)值孔徑物鏡,成像質(zhì)量高擴展性強
? 標配BGU三通道熒光,可按需定制單通或者雙通的高質(zhì)量濾光片組
? 長壽命LED激發(fā)光源,即開即用,觸屏直觀控制開關(guān),光強可調(diào),激發(fā)穩(wěn)定
? 高靈敏度相機,成像幀率更高,滿足更快速實時的高質(zhì)量熒光成像
? 搭配FISH軟件可實現(xiàn)多種熒光通道圖像快速、高精度合成

(3)病毒感染的組織切片和免疫組化切片常規(guī)觀測
推薦:ML51/ML41/ML31+顯微鏡相機MSX2、MSX1、MDX10、MD50等
? 無限遠平場消色差物鏡,滿足高質(zhì)量明場觀察,可擴展暗場相差等
? 真彩LED照明,明場狀態(tài)接近自然效果,減少視覺疲勞
? 配備高數(shù)值孔徑物鏡,分辨率高,細節(jié)觀測更清晰
? 為顯微成像優(yōu)化的Exmor CMOS相機,成像清晰細節(jié)豐富

(4)四大品牌熒光顯微鏡升級高靈敏度顯微鏡相機MSX2/MC50-S/MS23
? 針對弱光顯微成像優(yōu)化,靈敏度高,成像更快速,圖片更清晰
? 專業(yè)的適配接口搭配方案,目鏡和相機可以做到視野高度同步
? 可選雙分光接口,實現(xiàn)雙相機實現(xiàn)高幀率和高分辨率兼顧

(5)四大品牌顯微鏡熒光升級或LED熒光升級,數(shù)顯熒光模塊/熒光光源MG-100或MG-120 + 顯微鏡相機MC50-S等
? 數(shù)顯熒光模塊適合無限遠光學(xué)顯微鏡升級熒光觀察,高度整合,直觀數(shù)顯,即開即用
? LED熒光光源MG-100/MG-120可取代汞燈,為熒光顯微鏡帶來即開即用等升級體驗
? 常規(guī)免疫熒光檢測對實時性要求不高,可選MC50-S/MD60/MD50-T等顯微鏡相機
? 高實時性要求的研究級應(yīng)用,可選高靈敏度相機MSX2/MC50-S/MS23和配套FISH軟件
微信掃描二維碼,點擊右上角 ··· 按鈕
轉(zhuǎn)發(fā)給朋友或分享到朋友圈
<strike id="sgikq"></strike>